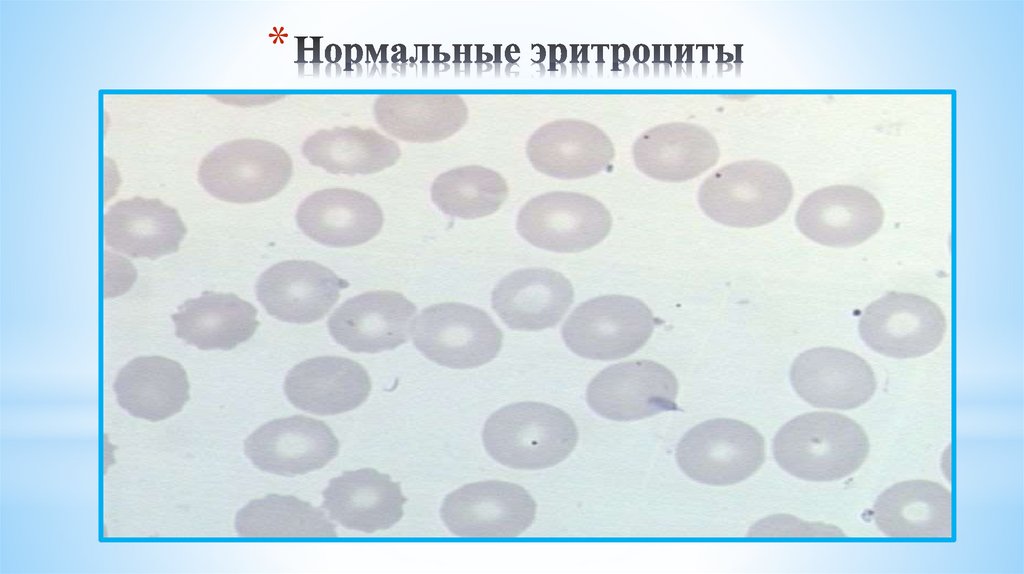

Похожие презентации:
Профилактика заболеваний кроветворной системы
1.
Тема занятияПрофилактика заболеваний кроветворной
системы
2 курс Л/Ф
Кафедра внутренних болезней,
клинической фармакологии и нефрологии
СЗГМУ им. И.И. Мечникова
2.
Цель занятияФормирование и развитие у обучающихся универсальных,
общепрофессиональных и профессиональных компетенций.
Научить студентов пропагандировать и реализовать на деле
здоровый образ жизни, воспитать гуманное отношение к людям,
бережное отношению к своему здоровью
3.
План практического занятия• 5 мин Вводная часть
• 10 мин Тестирование исходного уровня знаний
• 45 мин Теоретическая часть (в режиме диалога)
• 10 мин перерыв
• 60 мин Курация тематического больного (с преподавателем: разбор жалоб,
данных анамнеза, проведение объективного осмотра тематического больного)
• 20 мин перерыв
30 Обсуждение тематического больного в группе (разбор факторов риска,
обсуждение назначение профилактических мероприятий)
• 15 мин Тестирование усвоенных знаний
• 15 мин Заключение, подведение итогов
4.
1/ В организме взрослого человека1. содержится 4-5 г железа.
2. содержится 2-5 г железа.
3. содержится 10-12 г железа.
4. содержится 25-30 г железа.
2. В гемоглобине содержится
1. 60% имеющегося в организме железа
2. 10% имеющегося в организме железа
3. 30% имеющегося в организме железа
4. 90% имеющегося в организме железа
3. Суточная потеря железа в организме
1. 1-2 мг.
2. 8-10 мг.
3. 20-25 мг.
4. 25-50 мг.
4. Наиболее частая причина железодефицитной анемии
1. хронические кровопотери.
2. атрофический гастрит.
3. глистные инвазии.
4. алиментарные причины.
5. Суточная абсорбция железа в тонком кишечнике составляет:
1. 1,5-2мг.
2. 5-10мг.
3. 15-20мг.
4. 25-50мг.
5.
6. Препараты железа назначаются1. до нормализации гемоглобина, 2 недели для депо железа и далее курсами
2. на срок 1-2 недели
3. длительно, в течение 4-5 месяцев
4. сроком на 1 месяц
7. Прием каких препаратов ассоциируется с повышенным риском развития фолиево-дефицитной анемии
1. противосудорожных препаратов
2. бисопролола
3. каптоприла
4. преднизолона
8.
Какой фактор необходим для всасывания витамина В 12
1.
Гастромукопротеин
2.
Гастрин
3.
Соляная кислота
4.
Пепсин
6.
– раздел медицины, изучающий кровь,органы кроветворения и заболевание
крови.
*Врачей специализирующихся в области
гематологии называют гематологами.
*Их основная задача – лечение
пациентов с гематологическими
заболеваниями.
7.
8.
Актуальность темыЗаболеваний органов кроветворения актуальная и не вполне
решенная проблема современной гематологии.
Заболеваемость крови составляет в странах Европы порядка 2-13
на 100 тыс. населения в год и за последние 20 лет практически не
изменилась. Существует зависимость заболеваний крови от
возраста:
В группе 60 - 70 лет, 8,7 случаев 100 тыс. населения в год
В группе 71 - 80 и 24,5 случаев 100 тыс. населения в год
В группе >80 лет, соответственно 31,3
С. Aul и соавт. (1997) Национальный стандарт российской
федерации Клинические рекомендации (протоколы
лечения 2014)
9.
Северо-западный государственный медицинский университет им. И.И. МечниковаКлассификация
заболеваний крови
• В МКБ-10 (это общепринятая классификация
болезней) на заболевания системы крови
выделено более 90 наименований.
Санкт-Петербург
10.
Северо-западный государственный медицинский университет им. И.И. Мечникова• Распространена упрощенная классификация, согласно
которой вся патология крови делятся на четыре основные
группы:
1. анемии – сюда относят все патологические состояния, течение
которых сопровождается снижением уровня гемоглобина;
2. гемобластозы – опухолевые заболевания системы крови и
лимфоузлов;
3. геморрагические диатезы – патологии, связанные с
нарушением свертываемости;
4. другие заболевания крови.
Санкт-Петербург
11.
Источники информации• Литература основная:
• Профилактика заболеваний внутренних органов \ Радченко В.Г., Добрица В.П., Леонтьева Н.В.,
Аниконова Л.И., Полякова В.В., Селиверстов П.В., Ермолов С.Ю СПб.: Изд-во СЗГМУ им.
И.И.Мечникова-2016.- 48 с.
• Внутренние болезни. В 2 т. - 3-е изд., испр. и доп./ Под ред. В.С. Моисеева и др., - М.: ГЭОТАРМедиа, 2015.- Т.1.-958 с. ; Т.2.-895 с. ЭБС «Консультант студента.
• Внутренние болезни: Учебник для студентов мед. ВУЗов: В 2-х т. / А.С.Галявич М.: ГЭОТАР –
Медиа, 2004. - Т.1. – 585 с., Т.2. – 1227 с.
• Б) Дополнительная литература
• Внутренние болезни: Учебник для мед. ВУЗов. / С.И. Рябов3-е изд., испр. и доп. – СПб.: Спец.
Лит, 2004. – 879 с.
• Внутренние болезни: Учебник для студентов мед. ВУЗов: В 2-х т. / А.С.Галявич.- М.: ГЭОТАР –
Меди», 2001. - Т.1. – 585 с. (321 экз.), Т.2. – 1222 с.
• Профилактика заболеваний верхних отделов желудочно-кишечного тракта \ Мехтиева О. А.,
Радченко В. Г., Селиверстов П. В., Полякова В. В. СПб.: Изд-во СЗГМУ им. И.И.Мечникова-2015. - 48
с.
12.
Историческая справка Развитие теорий кроветворения.Три основных этапа развития гематологии .
Первое описание заболевания системы крови (хронической
железодефицитной анемии) было сделано в 1554 г. Johannes Lange, который
назвал его «болезнью девственниц» («De morbo virgineo»). Болезнь, которая
вскоре получила название хлороза, возникала у девушек в возрасте 14-17
лет. В 1600 г. Sydengam предложил использовать для лечения хлороза
.
препараты
железа
В 1832 г. Hodgkin сообщил о 6 случаях заболевания,
которое сопровождалось поражением
лимфатических узлов, селезенки, кахексией и
завершилось летальным исходом, где при
гистологическом исследовании не было выявлено
признаков инфекции, воспаления итд.
Источник: https://meduniver.com/Medical/gematologia/istoria_teorii_krovetvorenia.html MedUniv
13.
• В 1844 г. Solly описал больную (Sarah Newbury) смножественными переломами костей, возникавшими при
малейшем физическом воздействии. В последующем в
1873 г von Rustizky предложил название «множественная
миелома»
Термин «пернициозная анемия»
предложен Biermer (1872).
Длительное время заболевание
было известно как болезнь
Аддисона-Бирмера и лишь после
открытия витамина В12 в начале
1950-х годов получило
современное название.
Антон Бирмер
14.
Второй этап развития гематологииРазвитие теорий кроветворения.
• В начале 60-х годов XIX столетия сформировалось
понятие о кровяной ткани, включающей ткани
кроветворных органов (Hekkel, 1874).
• Сложилось представление о значении развития тканей
из зародышевых листков многоклеточных животных
(гастреи) для их классификации.
• В 1877 г. Hekkel отнес кровь к производным мезенхимы.
15.
• Расцвет описательнойгематологии связан с
именем P.Ehrlich.
• В 70-х годах XIX столетия
он применил специальные
методы окраски клеток
крови, с помощью которых
можно было изучать
элементы зернистости в
белых кровяных клетках.
16.
• Особое место в истории занимаетунитарная теория кроветворения
предложенная А. А. Максимовым. В своей
работе он использовал
экспериментальный гистологический
метод, который разработали И. И.
Мечников и А. О. Ковалевский.
Александр Александрович Максимов
А. А. Заварзин,
Большую роль в становлении унитарной
теории кроветворения
сыграли гематологи и гистологи нашей страны
А. А. Заварзин, А. Н. Крюков, А. В. Румянцев.
17.
Михаил Иннокентьевич Аринкин (1876-1948)• Исследование аспирата костного мозга при
сопоставлении с данными периферической
крови открыло новые закономерности,
позволившие лучше понять патогенез и
диагностировать большинство заболеваний
системы крови.
• Разработал метод стернальной пункции в
1927 год
• В последующем эта методика была
дополнена трепанобиопсией, пункциями
других кроветворных органов:
лимфатических узлов (предложена М. И.
Аринкиным в 1938 г.) и селезенки.
18.
• В изучении гемопоэза большуюроль сыграли И. А. Кассирский, Г.
А. Алексеев, М. С. Дульцин, Э. И.
Терентьева, В. А. Бейер, Ф. Э.
Файнштейн.
Иосиф Абрамович Кассирский
Георгий Алексеевич Алексеев
Неоднократно
переиздававшаяся монография
И. А. Кассирского и Г. А.
Алексеева «Клиническая
гематология», по сути,
подвела итог этих
исследований.
Источник: https://meduniver.com/Medical/gematologia/istoria_teorii_krovetvorenia.html MedUniv
19.
Третий этап развития гематологии 20-гопо 21-й века - иммуногематология.
• В последней четверти XX в. появилось еще одно научное и
практическое направление — иммуногематология.
• Иммунофенотипирование клеток крови и костного мозга,
иммуногистохимическое исследование ткани лимфатического узла,
селезенки, опухолевых образований стали обязательными методами
диагностики заболеваний системы крови, определения их прогноза и
тактики лечения.
• Методики радикальной лучевой терапии, моноклональных антител,
интерликинов, полихимиотерапии, трансплантации котного мозга
позволили существенно улучшить прогноз гематологических
больных.
Источник: https://meduniver.com/Medical/gematologia/istoria_teorii_krovetvorenia.html MedUniv
20.
21.
Различают : эмбриональный гемопоэз (происходит вэмбриональный период и приводит к развитию крови как ткани)
постэмбриональный гемопоэз (представляет собой процесс
физиологической регенерации крови).
Развитие:
эритроцитов называют эритропоэзом,
гранулоцитов — гранулоцитопоэзом,
тромбоцитов — тромбоцитопоэзом,
моноцитов — моноцитопоэзом,
лимфоцитов и иммуноцитов — лимфоцито- и иммуноцитопоэзом.
22.
Эмбриональный гемопоэзВ эмбриональном периоде выделяют 3 основных
этапа:
I.
II.
III.
Мезобластический,
Гепатолиенальный
Медуллярный.
23.
Мезобластический этап протекаетс 3-й по 9-ю неделю развития зародыша
человека.
Появляется первая генерация стволовых клеток крови
(СКК).
Происходит в мезенхиме стенки желточного мешка,
мезенхиме хориона и стебля.
24.
Начинается с 5—6-й недели развития плода.Печень становится основным органом гемопоэза, в ней
образуется вторая генерация стволовых клеток крови
которые заселяют печень тимус, селезёнку и
лимфатические узлы.
Кроветворение в печени достигает максимума
7-8 мес.
развития плода и завершается перед рождением.
25.
Появление третьей генерации стволовыхклеток крови костном мозге, где гемопоэз
начинается с 10-й недели и постепенно
нарастает к рождению.
После рождения костный мозг становится
центральным органом гемопоэза.
Кроветворение в костном мозге происходит
островками, состоящими из клеток
определённого вида.
Пролиферация и созревание, или
дифференцировка, клеток крови происходит
параллельно.
26.
процессфизиологической
регенерации крови,
который компенсирует
физиологическуюпотерю
дифференцированных
клеток.
27.
*Кроветворный костный мозг располагаетсяв губчатых
.
костях скелета и в эпифизах трубчатых костей у
взрослого человека.
28.
Родоначальница всех клеток крови – стволоваякроветворная клетка (СКК), которая может
развиваться в различные виды зрелых клеток.
Основные свойства СКК:
1. Полипотентность;
2. Способность к
самоподдержанию.
29.
I класс — СКК - стволовые клетки крови (плюрипотентные,полипотентные);
II класс — КОЕ-ГЭММ и КОЕ-Л - коммитированные
мультипотентные клетки;
III класс — КОЕ-М, КОЕ-Б и т.д. - коммитированные
олигопотентные и унипотентные клетки;
IV класс — клетки-предшественники (бласты, напр.:
эритробласт, мегакариобласт и т.д.).
V класс составляют созревающие клетки
VI класс зрелые клетки крови .
30.
31.
Необходимое условие для роста идифференцировки клеток крови –
взаимодействие стволовых кроветворных клеток,
кроветворного микроокружения и
гемопоэтических ростовых факторов.
32.
I.Кроветворное микроокружение
1. Механическую функцию (сохраняет структуру костного
мозга в кровотоке);
2. Индуцирует пролиферацию и дифференцировку СКК;
3. Передаёт информацию о потребностях организма в
тех или иных видах клеток;
4. Продуцирует различные ростовые факторы.
33.
Гемопоэтическиеколониестимулирующие факторы
(КСФ)
Цитокины определяют:
1. Выживаемость клеток
2. Стимуляцию роста,
3. Дифференцировку клеток,
4. Функциональную активацию
5. Апоптоз клеток.
34.
Цитокины – это низкомолекулярныебелковые вещества,
осуществляющие регуляцию
взаимодействий всех звеньев
иммунной системы.
В зависимости от того, какие клетки
преимущественно синтезируют тот или
иной цитокин, различают:
- интерлейкины,
- монокины
- лимфокины.
35.
36.
Общая характеристикагемопоэтических ростовых факторов
I. Обладают множественной биологической активностью.
II. Продуцируются различными видами клеток.
III. Как правило, оказывают действие более чем на одну
клеточную линию.
IV.Обычно действуют синергично с другими
гемопоэтическими ростовыми факторами.
37.
Клиническое применение ростовых факторов1) после лучевой и/или цитостатической терапии, трансплантации
гемопоэтических стволовых клеток (Г-КСФ, ГМ-КСФ);
2) мобилизация СКК перед трансплантацией
(Г-КСФ, ГМ-КСФ);
3) миелодиспластические синдромы (ГМ-КСФ и ИЛ-3);
4) апластическая анемия (ГМ-КСФ, ИЛ-3);
5) идиопатическая нейтропения (Г-КСФ);
6) тяжелые инфекции (стимуляция фагоцитов в сочетании
антибактериальной терапией).
с
38.
Каждая СКК образует одну колонию иназывается колониеобразующей единицей
(сокращенно КОЕ, CFU).
Существует две линии дифференцировки.
I. Линия даёт начало мультипотентной клетке — родоначальнице
гранулоцитарного, эритроцитарного, моноцитарного и
мегакариоцитарного рядов гемопоэза (сокращённо КОЕ-ГЭММ).
II. Линия даёт начало мультипотентной клетке — родоначальнице
лимфопоэза (КОЕ-Л).
39.
40.
1.2.
3.
4.
эритропоэтинов для эритробластов,
гранулопоэтинов для миелобластов,
лимфопоэтинов для лимфобластов,
тромбопоэтинов для мегакариобластов.
41.
• Основная часть гемопоэтических ростовых факторовпродуцируется Т-лимфоцитами, моноцитами
(макрофагами), эндотелиальными клетками и
фибробластами (стромальными клетками).
• Исключение составляет эритропоэтин, 90% которого
синтезируется в почках.
42.
• Тромбопоэтинсинтезируется в печени,
стимулирует
пролиферацию КОЕ-МГЦ,
их дифференцировку и
образование
тромбоцитов.
43.
• Тромбоциты являются частицами цитоплазмы гигантскойкостномозговой клетки — мегакариоцита.
• Мегакариоцит — уникальная клетка, развивающаяся по
эндомитотическому пути, т. е. митоз ядра не
сопровождается разделением цитоплазмы.
• В результате такого эндомитотического пути развития
образуются мегакариоциты с количеством ядер,
достигающим 128 к моменту созревания в их цитоплазме
тромбоцитов (основная часть мегакариоцитов содержит 8—
16 ядер).
44.
45.
• Эритропоэз у человека протекает в костном мозге в особыхморфофункциональных ассоциациях, получивших название
эритробластических островков.
• Эритробластический островок состоит из макрофага,
окружённого одним или несколькими кольцами эритроидных
клеток, развивающихся из унипотентной КОЕ-Э, вступившей в
контакт с макрофагом.
• КОЕ-Э и образующиеся из неё клетки (от проэритробласта до
ретикулоцита) удерживаются в контакте с макрофагом его
рецепторами.
46.
Этапы образования эритроцитаПервой морфологически распознаваемой клеткой эритроидного
ряда1 проэритробласт: (удвоение)
2 базофильных эритробласта I порядка:
4 базофильных эритробласта II поряда:
8 полихроматофильных эритробластов I порядка:
16 полихроматофильных эритробластов II порядка:
32 полихроматофильных нормобласта ->
32 оксифильных нормобласта-> денуклеация нормобластов->
32 ретикулоцита->
32 эритроцита.
47.
Гуморальным регулятором эритропоэза являетсягормон эритропоэтин.
Основным источником его у человека являются почки
— в них образуется до 85-90% гормона, остальное
количество вырабатывается в макрофагах.
Синтез и секреция эритропоэтина определяется
уровнем оксигенации почек которое зависит от
количества циркулирующих в крови эритроцитов.
(Продукцию эритропоэтина при гипоксии оно может
возрастать в 1000 и более раз).
48.
Снижение числа эритроцитов и соответственнопарциального давления кислорода, является сигналом для
увеличения продукции эритропоэтина.
Эритропоэтин действует на чувствительные к нему КОЕ-Э,
стимулируя их пролиферацию и дифференцировку, что в
конечном итоге приводит к повышению содержания в
крови эритроцитов.
49.
•Под давлением растущих островков кроветворнойткани в эндотелиальных клетках временно образуются
так называемые «миграционные поры» — узкие
отверстия диаметром 1 —1,2 мм, через которые зрелые
клетки проникают внутрь синусов.
• Для прохождения через такие узкие отверстия клетки
должны обладать эластичной мембраной, способностью
к деформации без повреждения и быстрому
восстановлению формы.
50.
Такое прохождение одних клеточных элементов сквозьдругие получило название эмпириополизиса.
51.
Снимки электронногомикроскопа
52.
*53.
*При попадании в периферическую кровь, эритроциты
осуществляют свои функции в системе циркуляции и
заканчивают жизнь спустя 100 — 120 дней в
ретикулогистиоцитарной системе преимущественно
селезёнки, подвергаясь фагоцитозу.
Продолжительность жизни тромбоцитов 5-7 дней.
Разрушаются преимущественно в печени и селезенки.
Лейкоциты - в среднем около 10 дней
54.
55.
Северо-Западный Государственный Университет им. И.И. Мечникова.Санкт-Петербург
56.
57.
Северо-Западный Государственный Университет им. И.И. Мечникова.Функции железа в организме
1. Транспорт кислорода
гемоглобином.
2. Синтез ДНК в составе коэнзима
редуктазы рибонуклеотидов.
3. Входит в состав многочисленных
митохондриальных энзимов.
Санкт-Петербург
58.
Северо-Западный Государственный Университет им. И.И. Мечникова.У здорового человека содержится около 3-4 г железа
(40-50 мг Fe/кг).
Санкт-Петербург
59.
Северо-Западный Государственный Университет им. И.И. Мечникова.Механизмы поддержании гомеостаза железа
1. Эритрофагоцитоз и рециркуляция
железа из эритроцитов, что
обеспечивает основные
потребности железа при
эритропоэзе (95%).
2. Абсорбция железа из продуктов
питания в тонком кишечнике,
которая в основном компенсирует
физиологические потери (5%)
Санкт-Петербург
60.
Северо-Западный Государственный Университет им. И.И. Мечникова.3. Система lRE/IRP (Iron
Responsive Element/Iron
Regulatory Protein)
внутриклеточное поступление
железа или его депонирование в
ферритине.
Санкт-Петербург
61.
Северо-Западный Государственный Университет им. И.И. Мечникова.Санкт-Петербург
62.
Северо-Западный Государственный Университет им. И.И. Мечникова.Количество железа в организме определяется
равновесием между поступлением и исходом
этого металла
Человеческий
организм не
имеет средств
контроля за
экскрецией
железа
Интестинальная абсорбция главный этап,
который тщательно
регулируется
Санкт-Петербург
63.
Северо-Западный Государственный Университет им. И.И. Мечникова.Регуляция этой абсорбции
находится под воздействием
1.
2.
3.
4.
Общего содержания железа в организме,
Эритропоэтической активности,
Наличия гипоксии
Особенностей питания.
Санкт-Петербург
64.
Северо-Западный Государственный Университет им. И.И. Мечникова.Санкт-Петербург
65.
Северо-Западный Государственный Университет им. И.И. Мечникова.• Гемовое железо- находится в
составе гемоглобина и
миоглобина в мясных
продуктах, усваивается
человеком на 20-30%
независимо от желудочной
секреции и состава пищи.
Санкт-Петербург
66.
Северо-Западный Государственный Университет им. И.И. Мечникова.• Негемовое железо
содержится в растительной
пище, усваивается человеком
1-7%, и во многом зависит от
сопутствующих пищевых
факторов.
Санкт-Петербург
67.
Северо-Западный Государственный Университет им. И.И. Мечникова.(Н.Д.ДУРМАНОВ, А.С.ФИЛИМОНОВ 2010)
Санкт-Петербург
68.
Северо-Западный Государственный Университет им. И.И. Мечникова.Регуляция интестинальной абсорбции
железа.
Интестинальная абсорбция
железа прямо
пропорционально
активности эритропоэза и
обратно пропорционально
количеству запасенного
железа.
Санкт-Петербург
69.
Северо-Западный Государственный Университет им. И.И. Мечникова.Эпителиальные клетки
запрограммированы на абсорбцию
железа на уровне зрелых клеток
ворсинок. Этот процесс
разворачивается в течение двух трех
дней.
Связан с миграции полипотентных
клеток-предшественников,
находящихся внутри кишечных
крипт, на ворсинки.
Санкт-Петербург
70.
1.Витамин Е (а-токоферол) осуществляет защитумембран эритроцитов от перекисного окисления,
усиливающего гемолиз эритроцитов.
2.Витамин РР (никотиновая кислота). Защиту
гемоглобина и мембраны эритроцитов от окисления.
3.Витамин В2 ( рибофлавин) участвует в
окислительно-восстановительных реакциях и его
дефицит вызывает у человека анемию
гипорегенеративного типа.
71.
4. Витамин В12 необходима для синтезануклеопротеинов, необходимых для созревания и
деления ядер клеток.
5. Витамин В9 (Фолиевая кислота ) поддерживает
синтез ДНК в клетках костного мозга
6. Витамин В6 (пиридоксин) является кофактором
(т.е. дополнительным фактором активности) АЛКсинтетазы участвующей в образовании гема в
эритробластах, и его дефицит вызывает анемию
вследствие нарушенного гемоглобинопоэза.
7. Витамин С поддерживает основные этапы
эритропоэза, способствуя метаболизму фолиевой
кислоты в эритробластах. Он участвует в метаболизме
железа.
72.
1. Медь, обеспечивающая лучшее всасывание железа вкишечнике и мобилизацию его резерва из печени и
ретикулярных клеток;
2. Никель и Кобальт, имеющие отношение к синтезу
гемоглобина и гемсодержаших молекул, способствующих
утилизации железа.
Их недостаток вызывает анемию (например, в районах, где почвы бедны этими
микроэлементами).
73.
3.Селен, тесно воздействуя с витамином Е,защищает мембрану эритроцита от
повреждения свободными радикалами.
4.Цинк, почти 75% всего цинка в организме
человека находится в эритроцитах, в составе
фермента карбоангидразы. Недостаток цинка
вызывает лейкопению.
74.
За 70 лет жизни в кроветворных органахпродуцируется около:
275 кг лимфоцитов
460 кг эритроцитов
5400 кг гранулоцитов
40 кг тромбоцитов
75.
76.
*Анемия (αν с др.-греч. — «недостаток»; αιμία с др.-греч. —«кровь») или малокровие — группа клинико-гематологических
синдромов, общим моментом для которых является снижение
концентрации гемоглобина в крови, чаще при одновременном
уменьшении числа эритроцитов (или общего объёма
эритроцитов).
*Термин «анемия» без уточнения не определяет конкретного
заболевания, то есть анемию следует считать одним из
симптомов различных патологических состояний.
77.
1. По цветовому показателю2. По степени тяжести
3. По способности костного мозга к регенерации
4. Патогенетическая классификация
5. По этиологии
78.
1 Гипохромная анемия (ЦП < 0,8)2 Нормохромная анемия (ЦП 0,8—1,05)
3 Гиперхромная анемия (ЦП > 1,1)
79.
от 119 до 90 г/л легкая степень малокровия.ниже 70 г/л - тяжелая форма малокровия.
от 89 до 70 г/л - малокровие средней
тяжести.
80.
Основным признаком такой регенерации является увеличение количестваретикулоцитов (молодых эритроцитов) в периферической крови. Норма 0,5 2 %.
• Арегенераторная —отсутствие ретикулоцитов.
• Гипорегенераторная количество ретикулоцитов ниже 0,5 %.
• Норморегенераторная или регенераторная — количество ретикулоцитов в
норме (0,5—2 %).
• Гиперрегенераторная
— количество ретикулоцитов более 2 %.
81.
Основана на механизмах развития анемий как патологического процессаЖелезодефицитные анемии — связаны с дефицитом железа
Апластические анемии — связанные с нарушением кровообразования в
красном костном мозге
Постгеморрагические анемии — связанные с острой или хронической
кровопотерей
Гемолитические анемии — связанные с повышенным разрушением
эритроцитов
В12 — и фолиеводефицитные анемии
82.
При инфекциях: туберкулёз, бактериальный эндокардит,бронхоэктатическая болезнь, абсцесс лёгкого, бруцеллёз,
пиелонефрит, остеомиелит, микозы.
При коллагенозах: системная красная волчанка, ревматоидный
артрит, узелковый полиартериит, болезнь Хортона
83.
Основные механизмыразвития анемии:
84.
Основные механизмы развития анемии:Анемия как следствие нарушения образования
нормальных эритроцитов и синтеза гемоглобина.
Анемия как следствие потери эритроцитов.
Анемия как следствие ускоренного разрушения
эритроцитов крови.
85.
86.
Северо-Западный Государственный Университет им. И.И. Мечникова.Железодефицитные
анемии
Санкт-Петербург
87.
Северо-Западный Государственный Университет им. И.И. Мечникова.По данным ВОЗ скрытым дефицитом железа или клинически
выраженной ЖДА страдает около 2 миллиардов человек.
Из доклада совместного комитета ЮНЕСКО и ВОЗ по политике в
области здравоохранения в среднем около 40% женщин
репродуктивного возраста страдают железодефицитной анемией.
По многочисленным данным ЖДА составляет 75-95% всех анемий
беременных.
В России около 12% женщин детородного возраста страдают ЖДА, а
латентный дефицит железа в некоторых регионах России достигает
50%.
Санкт-Петербург
88.
Северо-Западный Государственный Университет им. И.И. Мечникова.Этиология.
• Основной причиной развития ЖДА является несоответствие между
поступлением железа и его расходом (потерями), в результате чего происходит
постепенное истощение запасов железа в организме, а в дальнейшем и снижение
содержания тканевого и других форм железа.
Среди наиболее частых причин значение имеют :
хронические кровопотери различной локализации (желудочно-кишечные, маточные,
носовые, почечные) вследствие различных заболеваний;
нарушение всасывания поступающего с пищей железа в кишечнике (энтериты,
резекция тонкого кишечника, синдром недостаточного всасывания, синдром «слепой
петли»)
повышенная потребность в железе (беременность, лактация, интенсивный рост и др )
алиментарная недостаточность железа (недостаточное питание, анорексии
различного происхождения, вегетарианство и др.).
Санкт-Петербург
89.
Северо-Западный Государственный Университет им. И.И. Мечникова.Меры первичной государственной и
индивидуальной профилактики ЖДА
Санкт-Петербург
90.
Меры государственной профилактики• Если распространенность ЖДА в стране или регионе
превышает 40%, эксперты ВОЗ рекомендуют проведение
фортификации.
• Фортификация - обогащение продуктов питания
массового и регулярного потребления недостающими
компонентами пищи, является одним из доступных и
эффективных методов профилактики социально-значимых
микронутриентных дефицитов.
91.
• Фортификация которая предусматриваетобогащение железом наиболее употребляемых
населением продуктов.
• Обычно в качестве таких 13 продуктов
выбирают хлеб или макаронные изделия.
• Важно, чтобы доля населения,
употребляющего этот продукт, составляла не
менее 65–95%.
92.
• К сожалению фортификация затруднена из-за отсутствияидеального пищевого продукта, хорошо переносимого
соединения железа, а также проблем с его
всасываемостью.
• Эффективность фортификации составляет около 50%
среди охваченного населения.
93.
Северо-Западный Государственный Университет им. И.И. Мечникова.Содержание железа (в мг) в некоторых продуктах питания
(Дроздов В.Н. 2007.)
«Бедные»
<0,9 мг в 100 г
продукта
Морковь, гранат,
клубника, виноград,
апельсин, мандарин,
коровье молоко,
сливочное масло.
«Средние»
от 1,0 до 4,9 мг
в 100 г продукта
«Богатые»
5,0 мг > в 100 г
продукта
Телятина, Говядина, печень
Крупа пшеничная и овсяная, мука гречневая свиная, говяжья, толокно,
и овсяная, баранина, говядина, шпинат,
желток куриного яйца
яблоки, яйцо куриное, черная смородина,
икра кетовая, крупа манная, курица, рис,
картофель, капуста.
Санкт-Петербург
94.
Северо-Западный Государственный Университет им. И.И. Мечникова.• Употребление чая, – танин – снижает всасывание
железа на 62%
• При совместном приеме молочных продуктов
усвоение железа уменьшается на 50%.
• Употребление приправ, майонезов, соусов
содержащим ЭДТА (этилендиаминтетрауксусная
кислота), снижает усвоение железа на 25%.
Санкт-Петербург
95.
• Более эффективной считаетсяпрофилактика ЖДА у населения,
представляющего группы риска
развития анемии.
• Этот вид профилактики получил
название саплиментации (От
англ. supplement – дополнение) и
подразумевает добавку веществ
(железа.) извне.
96.
В настоящее время первичная профилактика дефицитажелеза в большинстве стран касаются:
1.Детей раннего возраста.
2.Беременных и кормящих женщин,
3.Детей, находящиеся на искусственном вскармливании и
получающие молочные смеси, обогащенные железом
4. Цельное коровье молоко не следует назначать детям до 12
мес.
5. Дети в возрасте 6–12 мес. должны получать 11 мг железа в
сутки.
97.
Наиболее показательным примером саплиментации являетсяприменение препаратов железа у беременных женщин для
профилактики ЖДА.
98.
• Согласно рекомендациям ВОЗ, препарат железа вдозе 60 мг/кг в сутки применяют во II и III
триместрах беременности и в течение 3 мес.
лактации.
• Национальные рекомендации США предусматривают
применение препарата железа в дозе 30 мг/кг в
сутки в течение всего периода беременности.
• Однако даже при охвате саплиментацией 50, 80 и
95% беременных женщин эффективную дозу железа
получают только 67% женщин.
99.
• В качестве блюд прикормаследует назначать красное мясо
и овощи с высоким
содержанием железа.
• В случае недостаточного
поступления железа с
молочными смесями или
прикормом следует
дополнительно назначить
железо в виде капель или
сиропа;
100.
101.
Вторичная профилактика дефицита железа показана тем больным, у которых
причина, приведшая к дефициту железа не устранена. (Рекомендовать приём
препаратов железа в течение 7 - 10 дней каждого месяца.)
Профилактическое применение препаратов железа необходимы донорам,
постоянно сдающим кровь, беременным женщинам в тех случаях, когда
беременности предшествовали обильные менструации или же когда
беременность следует одна за другой.
102.
Вторичную профилактику дефицита железа (ранняядиагностика ЖДА) рекомендуется проводить при каждом
обращении пациента к врачу, проведении диспансеризации,
медицинских осмотров и т.д.
В качестве меры вторичной профилактики ЖДА в
предусмотрен универсальный и селективный скрининг.
103.
Определение концентрации HbОценку факторов риска развития ЖДА.
Факторам риска относят:
1. Низкий социально-экономический статус семьи (социально неблагополучные
семьи, беженцы или эмигранты);
2. Диета с низким содержанием железа (Вегетарианство).
3. Недоношенность или низкая масса тела при рождении;
4. Отравление свинцом;
5. Исключительно грудное вскармливание после 4-месячного возраста без
дополнительного назначения железа; употребление цельного коровьего
молока
104.
1.Недостаточное питание2.Отставание в развитии
3.Особые потребности, обусловленные
состоянием здоровья.
105.
У всех небеременных женщин начиная с подросткового возраста,скрининг для выявления анемии проводят каждые 5–10 лет в
течение всего детородного возраста.
Ежегодному скринингу подлежат женщины с факторами риска
развития ЖДА (обильная кровопотеря при менструации или иной
природы, недостаточное потребление железа и предшествующий
диагноз ЖДА).
106.
При проведении скрининга популяции с низкой распространенностью ЖДА иотсутствием тяжелых форм заболевания следует ориентироваться изменения
лабораторных показателей тк. они обладают наибольшей точностью и
эффективностью.
Клинический анализ крови
1. Hb,
2. гематокрит,
3. цветовой показатель,
4. MCV (Средний объем эритроцита)
5. MCH (Среднее содержание гемоглобина в эритроците)
Биохимические показатели
(Сывороточное железо, общее железосвязывающая способность плазмы,
ферритин, трансферин),
107.
Распознавание причины развития ЖДА вкаждом конкретном случае является конечным
этапом диагностического поиска.
Ориентация на нозологическую диагностику
очень важна, так как в большинстве случаев
при лечении анемии целесообразно можно
воздействовать на основной патологический
процесс.
108.
*Лечение больного ЖДА складывается из трех компонентов.1. Первым и основным действием врача должно быть направлено на
выявление, а затем, по возможности, и устранение причины
развившегося малокровия.
2.Вторым этапом лечебного процесса - заместительная терапия
препаратами железа
3. Третий этап - организация адекватного питания
*Однако следует обратить внимание
на то, что рациональная
диета, способствуя выздоровлению и профилактике рецидивов
заболевания , сама по себе не может компенсировать уже
развившийся дефицит железа с клиническими проявлениями.
109.
110.
111.
1.Количество двухвалентного железа2.Наличие в препарате веществ,
улучшающих всасывание железа
3.Переносимость препарата
112.
ДефицитЖелеза
Мать
Ребенок
Анемия.
Утомляемость.
Недоношенность.
Снижение сопротивляемости
Неонатальная
инфекциям.
смертность.
Слабость родовой
Нарушение
деятельности
умственного развития.
Патология беременности
113.
114.
B12-дефицитная анемия(устаревшее название)
1.Перницио́зная анеми́я (от лат. perniciosus —
гибельный, опасный)
2.Мегалобластная анемия
3.Болезнь Аддисона-Бирмера
4.Злока́чественное малокро́вие
115.
Первое описание этого заболевания сделал Кумбс в 1822г. и назвал его тяжелым первичным малокровием.
В 1855 г. врач Аддисон описал это страдание под
названием «идиопатическая анемия».
В 1872 г. Бирмер опубликовал результаты наблюдения за
группой больных, страдавших прогрессирующей
пернициозной анемией.
Однако возможность излечения этого заболевания
появилась только в 1926 г., когда Майнот и Мерфи
обнаружили выраженный лечебный эффект от назначения
сырой печени.
116.
Через три года американский физиолог Кастл показал, чтосырое мясо, печень, дрожжи, обработанные желудочным
соком здорового человека, обладают свойством вызывать
ремиссию у больного пернициозной анемией.
Исследования Кастла легли в основу концепции, согласно
которой в результате взаимодействия двух факторов –
внешнего, содержащегося в сыром мясе, сырой печени,
дрожжах, и внутреннего, вырабатываемого слизистой
оболочкой желудка, создается антианемическое
соединение, которое обеспечивает физиологическое
вызревание костномозговых клеток.
117.
*1.Нарушения всасывания витамина B12 вследствие
снижения или отсутствии секреции внутреннего фактора.
2.Нарушение всасывания В12 в тонком кишечнике в
результате хронического энтерита или глютеновой
энтеропатии;
3.Длительное снижение внешнесекреторной активности
поджелудочной железы, следствием чего является
нарушение расщепления протеина R, без которого
витамин В12 не может связаться с мукополисахаридом;
118.
119.
Конкурентное поглощение витамина В12 втонком кишечнике широким лентецом или
микроорганизмами;
120.
Первичная профилактика• своевременное и правильное лечение заболеваний
желудка и кишечника, рациональное питание.
• При ботриоцефальной В12 дефицитной анемии
заключается в профилактическом обследовании лиц,
предпочитающих употреблять в пищу термически
необработанную рыбу, на глистоносительство и в
частности на зараженность широким лентецом. В
необходимых случаях проводится дегельмитизация.
121.
122.
123.
• Анемии, обусловленные дефицитом фолиевой кислоты,характеризующиеся появлением в костном мозге
мегалобластов, внутрикостномозговым разрушением
эритроцитов, психическими расстройствами.
Суточная потребность в фолиевой кислоте составляет 100—200
мкг. Общее количество фолиевой кислоты в диете при
полноценной питании составляет 400 — 600 мкг в сутки.
124.
Дети до 6 месяцев40-50мкг
7-12 месяцев
120 мкг
1-12 лет
200мкг
12 лет и старше
400 мкг
Взрослые
400 мкг
Беременные
женщины
Кормящие
женщины
800 мкг
600 мкг
125.
*126.
Наблюдается :1. Перенёсших резекцию части тощей кишки,
2. При тропической спру и целиакии,
3. При синдроме слепой петли.
4. У лиц, длительно принимающих противосудорожиые
препараты типа дифенилгидантоина (дифенин) и
фенобарбитала,
5. Страдающих алкоголизмом.
127.
У лиц перенёсших резекцию части тощей кишки, притропической спру и целиакии, при синдроме слепой петли.
Во время беременности.
Во время длительного приема противосудорожных препаратов
типа дифенилгидантоина (дифенин) и фенобарбитала,
При гемолитических анемиях.
При злоупотреблении алкоголя.
При постоянном употреблении термически обработанной пищи.
128.
ДефицитМать
Ребенок
Фолиевой Кровотечения. Гипотрофия
кислоты Выкидыши.
Неврологические
Послеродовые нарушения депрессии
дефекты развития
невральной трубки
129.
Должна проводиться и лиц страдающихнаследственными и приобретенными формами
гемолитической анемии, талассемии.
Доза фолиевой кислоты при этом должна быть не
более 5 мг в сутки.
130.
В профилактическом приеме фолиевой кислотынуждаются беременные, больные с талассемией,
гемолитической анемией. В целях предупреждения
патологии плода и акушерских осложнений прием
фолиевой кислоты по 0,4 мг/сутки необходимо
начинать еще в рамках прегравидарной подготовки (за
несколько месяцев до зачатия) и продолжать на
протяжении всей беременности и грудного
вскармливания. Известно, что профилактический
прием фолиевой кислоты, начатый еще до
наступления беременности, позволяет снизить частоту
рождения детей с врожденными пороками ЦНС в 3,5
раза.
Источник:
https://www.krasotaimedicina.ru/diseases/hematologic/fola
te-deficiency-anemia
131.
132.
АА -состояние, при котором резкоугнетено кроветворение, то есть
имеет место аплазия (гипоплазия)
костного мозга, следствием чего
является развитие анемии,
лейкопении и тромбоцитопении.
Заболевание чаще возникает в
молодом и среднем возрасте.
133.
Апластическаяанемия впервые
описана
П.Эрлихом в 1888г.
134.
**Причины угнетения кроветворения
окончательно не установлены.
*В одних случаях она генетически
обусловлена и связана с дефектами
развития столовой клетки, а в других
аплазия кроветворения возникает
вследствие воздействия внешних
факторов.
135.
*Забор костного мозга136.
*137.
*138.
*Соблюдение техники безопасности при работе с
источниками ионизирующего излучения, бензолом и
другими красителями,
Контроль при применении лекарственных препаратов,
обладающих миелотоксическим действием,
Лечение заболеваний внутренних органов, при которых
возможно угнетение кроветворения (циррозы печени,
гипотиреоз, хронические холециститы, заболевания
почек).
Длительное диспансерное наблюдение за больными, в том
числе с полными ремиссиями заболевания, контроль за
показателями крови.
139.
*Для предупреждения ухудшения состояния
пациентов, у которых заболевание уже
развилось, применяется вторичная
профилактика, которая предполагает:
1. диспансерное наблюдение за пациентом на
протяжении длительного времени, это также
касается пациентов, у которых наблюдаются
признаки выздоровления;
2. длительная (многолетняя) поддерживающая
терапия.
140.
Проверка усвоенных знаний(тестирование, выбрать 1 правильный ответ)
Истончение и деформации ногтевых пластинок, сглаженность сосочков языка, затруднение
глотания сухой пищи относятся к:
1.
сидеропеническому синдрому при Fe-дефицитной анемии
2.
проявлениям общеанемического синдрома
3.
синдрому фуникулярного миелоза при В12- дефицитной анемии
4.
гемолизу при гемолитической анемии
2. Беременной женщине с железодефицитной анемией следует:
1.
принимать внутрь препарат железа до родов и весь период кормления ребенка грудью
2.
перелить эритроцитарную массу перед родами
3.
внутривенные инъекций препаратов железа
4.
в рацион питания ввести телятину, говядину
141.
3. У больного, страдающего Fe-дефицитной анемией могут определяться такие характерные симптомы,как:
1.
повышенная ломкость ногтей, сглаженность сосочков языка, затруднение глотания сухой пищи
2.
отставание в физическом развитии
3.
неврологические нарушения, глоссит
4.
приступообразные боли в животе и поясничной области, сопровождающиеся повышением
температуры
4. Для железодефицитной анемии характерно:
1.
снижение уровня ферритина и повышение ОЖСС
2.
повышение уровня непрямого билирубина в сыворотке крови
3.
повышение уровня ферритина и снижение ОЖСС
4.
обнаружение в моче метилмалоновой кислоты
142.
5. Нормальный показатель уровня гемоглобина крови1.
120-150 г/л.
2.
100-120 г/л.
3.
140-160 г/л.
4.
50-170 г/л.
6. Наиболее частая причина железодефицитной анемии
1.
хронические кровопотери.
2.
атрофический гастрит.
3.
глистные инвазии.
4.
алиментарные причины.
5.
диарея.
7. Причиной железодефицитной анемии у беременной женщины может быть:
1.
имевшийся ранее латентный дефицит железа.
2.
многоплодная беременность.
3.
несовместимость с мужем по системе АВО.
4.
атрофический гастрит
143.
8. Самой частой причиной железодефицитной анемией у мужчин является:1.
кровопотеря из желудочно-кишечного тракта
2.
атрофический гастрит
3.
алкогольный гепатит
4.
гематурическая форма гломерулонефрита
9. Генез железодефицитной анемии у женщин можно непосредственно связать со следующими
данными анамнеза:
1.
большим количеством беременностей и родов, длительное кормление грудью.
2.
резекцией желудка
3.
нефрэктомией
4.
гипосекреторным гастритом
10 Для лечения дефицита железа следует назначать:
1.
препараты железа внутрь на длительный срок.
2.
препараты железа внутривенно в сочетании в мясной диетой
3.
препараты железа внутривенно в сочетании с витаминами группы В и С в/м.
4.
регулярные трансфузии эритроцитарной массы в сочетании с богатой фруктами диетой.
144.
Северо-западный государственный медицинский университет им. И.И. МечниковаСеверо-Западный Государственный
Медицинский Университет
им. И.И. МЕЧНИКОВА
Санкт-Петербург

Медицина
Медицина








